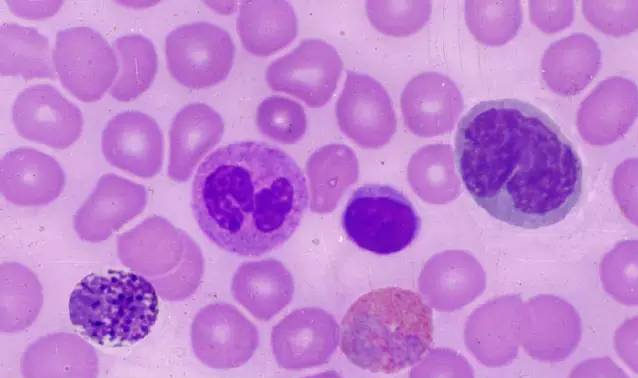
血液知识：【临床】识别血细胞的方法和要点

血液知识:【临床】识别血细胞的方法和要点
685 0
2018-10-19
血液知识:【临床】识别血细胞的方法和要点
识别血细胞时一定要细心,根据血细胞的结构和发育演变规律,再来定该细胞的类型。一般按以下程序进行,即细胞的大小形态、边缘是否整齐、有无伪足突出、核浆的比例、浆的多少和色泽、颗粒的有无、性质、多少、大小和分布情况;核的大小形态、核染色质结构及核仁的有无、数目、大小、形态和染色等,不能只就细胞的粗略外观来定该细胞的类型。血液细胞形态学的识别有一定的规律,在识别时要按“核浆兼顾,以核为主”的原则。再遵循胞体、胞浆、胞核、核仁、的次序“从外向里”一步一步地细心检查和分析。
因此,在看细胞时还要注意细胞核内染色质和染色体的变化,如原红细胞核染质呈颗粒状、巨核细胞核染质呈条索状、浆细胞核染质呈块状、单核及组织细胞核染质呈网状结构等。染色体短粗,胞浆鲜蓝色为原淋巴细胞、胞浆深蓝色为原红细胞;染色体细长,胞浆灰蓝色为幼单核细胞、胞浆淡蓝色且有颗粒为幼粒细胞等等。
虽然,血液细胞千变万化,各自不同,但各系统在同一成熟阶段,都可以找出共同的特征。如各系的原始阶段细胞,浆均较少,嗜碱性较本系统其他阶段为强,无颗粒,浆纯净。核染色质是很细致的,副染色质不明显,均可见数目不等的核仁。随着细胞逐渐成熟过和中检验地带网,浆中颗粒也随之增多,核染色质由细致逐渐变为粗糙,核仁也随之而不清晰,以至消失。各阶段的细胞随着分化发育的成熟,各自表现的特征趋于明显。因此,区分细胞的困难在各系统原始阶段(如初生之婴儿)及两个相近阶段(如孪生姊妹)细胞之间的鉴别。
在识别幼稚细胞所属系统有困难时,可寻找与该细胞相似而又较成熟的细胞加以推测。因为细胞愈成熟,特点愈多,愈易于识别。这就是不要孤立地看其一个特征,而是要和其他较成熟之细胞来作比较,从较成熟细胞的特征来旁证该幼稚细胞的类型,这将有助于对幼稚细胞所属系统作出正确的结论。
血液细胞发育演变在正常情况下是同步的平衡规律,即年幼的核配年幼的浆,成熟的核配成熟的浆。正是由于这些细胞发育演变的平衡规律,使我们有可能将血细胞的成熟演变人为地划分成几个阶段。成熟的过程是连续不断的,并无突然变化。有时可见界于两阶段之间的过渡形态,很难命名为前一阶段的后期,或后一阶段的前期。在判断时,一般划为较成熟的阶段。
但在病理情况而发生异步,造成核浆发育紊乱。所有细胞形态发生畸变,往往造成辨认上的困难,即使有经验的人,也难以确认属何系统何阶段。在这种情况下,就要借助细胞化学染色或其他方法,来协助定型。如实在无法定型,暂可划入分类不明栏内,将形态特征进行描述。

要养成全面综合分析的良好习惯,切忌单凭一两种特点而片面即下结论。初学时遇到难以识别细胞,也可请教他人协助解决。宁可看得仔细而少看,不要贪多马虎放过识别的机会。做任何事情在开始在时候总会遇到很多艰难和困阻,学习血液细胞也是这样,它不是一朝一夕就能掌握,但只要在实践中不断地边学边看,就一定会成功的。这对许多血液病的临床诊断和治疗会有很大的帮助,只有得出正确的诊断,才能更好地为病人服务。以上识别方法与要点,仅供参考,望能认真遵循。
识别细胞要细心,按其结构定类型;核浆兼顾核为主,从外向里细区分。
原始浆纯核细致,成熟质粗无核仁;幼稚阶段难识别,多从成熟找特征。
病理形态多畸变,结合组化再定型;全面综合和分析,切忌片面下结论。
边学边看多实践,全心全意为病人;以上方法与要点,供君参考和遵循
您可能感兴趣的



